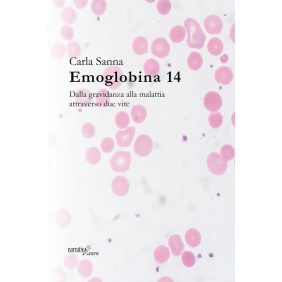

Home
-
- Importati
- VINI
- Prodotti Tipici
- PASTICCERIA
- BIRRA ARTIGIANALE
- PRODOTTI DA FORNO
- OLIO
- PASTA
- CONSERVE SOTTOLI
- VINCOTTO
- ACETI
- CONFEZIONE
- FORMAGGI E SALUMI
- SUGHI SALSE
- THE
- LIQUORI
- DOLCI
- OLI E ACETI
- SPEZIE AROMI
- CAFFE
- GASTRONOMIA
- PRIMI PIATTI
- PANE PIZZE FOCACCE
- SUCCHI DI FRUTTA
- CIOCCOLATO
- FORMAGGI
- CESTO LETTERARIO
- ENOGASTRONOMIA
- CUCINA DEL TERRITORIO
- SENZA CATEGORIA
- Reparti
- ARTI
- ARTI: ARGOMENTI D'INTERESSE GENERALE
- STORIA DELL'ARTE: STILI ARTISTICI
- Stili artistici (non classificati per data)
- Arte dei popoli indigeni
- Arte naif
- Arte orientale
- Arte coloniale
- Storia dell'arte: arte preistorica
- Storia dell'arte: arte antica e classica fino al 500 d.C.
- Storia dell'arte: arte bizantina e medievale dal 500 d.C. al 1400 d.C.
- Storia dell'arte e stili artistici: dal 1400 al 1600
- Arte rinascimentale
- Stili artistici: Manierismo
- Storia dell'arte e stili artistici: dal 1600 al 1800
- Stili artistici: Barocco
- Stili artistici: Neoclassicismo
- Storia dell'arte e stili artistici: dal 1800 al 1900
- Stili artistici: Romanticismo
- Stili artistici: Arte pre-raffaellita
- Stili artistici: Movimento Arts & Crafts
- Stili artistici: Impressionismo e Post-Impressionismo
- Stili artistici: Art nouveau
- Storia dell'arte e stili artistici: dal 1900 in poi
- Storia dell'arte e stili artistici: dal 1900 al 1960 circa
- Stili artistici: Espressionismo
- Stili artistici: Design modernista e Bauhaus
- Stili artistici: Art Deco
- Stili artistici: Cubismo
- Stili artistici: Surrealismo e Dadaismo
- Stili artistici: Espressionismo astratto
- Stili artistici: dal 1960 circa
- Stili artistici: Pop art
- Stili artistici: Minimalismo
- Stili artistici: Arte concettuale
- Stili artistici: Postmoderno
- FORME D'ARTE
- Pittura e tecniche della pittura
- Pittura ad acquerello
- Pittura a olio
- Disegni e tecniche del disegno
- Stampe e tecniche di stampa
- Altre forme di arte grafica
- Collage e fotomontaggi
- Graffiti e arte di strada
- Forme d'arte non grafiche
- Scultura
- Arte dell'intaglio
- Metalli e pietre preziose: opere d'arte e design
- Installazioni
- Performance art
- Arte elettronica, video-arte e arte olografica
- Arte della ceramica, della porcellana e del vetro
- Ceramica: opere d'arte
- Mosaico: opere d'arte
- Vetro al piombo: opere d'arte
- Arti decorative
- Arte folk
- Opere d'arte tessile
- Opere d'arte tessile: tappeti
- Opere d'arte tessile: arazzi, tappezzerie e quilt (trapunte)
- Body art e tatuaggi
- ARTI: SOGGETTI E TEMI SPECIFICI
- Singoli artisti, monografie d'arte
- Cataloghi di mostre e specifiche collezioni
- Figure umane nell'arte
- Ritratti nell'arte
- Nudi nell'arte
- Arte erotica
- Scene famigliari, in scala ridotta e non-religiose
- Animali e natura nell'arte (nature morte, paesaggi, marine ecc.)
- Arte botanica
- Manufatti nell'arte (paesaggi urbani, macchine ecc.)
- Soggetti religiosi nell'arte
- Arte: tecniche e principi
- FOTOGRAFIA E FOTOGRAFI
- ARTE E DESIGN INDUSTRIALE E COMMERCIALE
- Singoli designer
- Design grafico
- Tipografia e disegno dei caratteri
- Illustrazione e grafica pubblicitaria
- Illustrazione
- Fumetti e cartoni animati
- Narrativa a fumetti e manga
- Poster
- Design dei prodotti
- Design dei mobili
- Design tessile e della moda
- Design e teoria della moda
- Storia del costume
- Design e teoria dei tessuti
- ARCHITETTURA
- Teoria dell'architettura
- Singoli architetti e studi di architettura
- Architettura e design degli edifici
- Architettura e design eco-compatibili
- Architettura: pratica professionale
- Edifici pubblici: edifici civili, commerciali, industriali ecc.
- Sale da concerto, arene, stadi, teatri
- Monumenti commemorativi
- Edifici residenziali, case
- Case, appartamenti, abitazioni
- Palazzi, ville, case di campagna
- Castelli e fortificazioni
- Edifici religiosi
- Architettura di interni
- Arte e architettura del paesaggio
- Pianificazione urbanistica, aspetti architettonici
- Storia dell'architettura
- STUDI TEATRALI
- CINEMA, TELEVISIONE E RADIO
- Singoli attori e interpreti
- Cinema, film
- Teoria e critica del cinema
- Singoli registi e produttori
- Soggetti e sceneggiature cinematografiche
- Guide ai film e recensioni cinematografiche
- Cinema: stili e generi
- Documentari
- Film d'animazione
- Produzione cinematografica: professioni tecniche
- Televisione
- Soggetti e sceneggiature televisive
- Soap opera
- Produzione televisiva: professioni tecniche
- Radio
- Sceneggiature radiofoniche
- DANZA E ALTRE ARTI DELLO SPETTACOLO
- Danza
- Coreografia
- Balletto
- Balli di sala
- Danza contemporanea
- Ballo popolare e folk
- Altre arti dello spettacolo
- Mimo
- Teatro di strada
- Giochi di prestigio e magia
- Varietà, music hall, cabaret
- Giochi di destrezza (giocoleria)
- Teatri dei burattini, teatri in miniatura e teatri giocattolo
- Sagre, celebrazioni, sfilate, festival
- Circo
- Spettacoli con animali
- MUSICA
- Teoria della musica e musicologia
- Recensioni e critica musicale
- Discografie e guide all'acquisto
- Musica: stili e generi
- Musica classica occidentale
- Musica antica (fino al 1000 d.C.)
- Musica medievale e rinascimentale (dal 1000 al 1600)
- Musica barocca (dal 1600 al 1750)
- Musica classica (dal 1750 al 1830)
- Musica romantica (dal 1830 al 1900)
- Musica classica del 20. Secolo e contemporanea
- Musica corale
- Opera
- Musica sacra e religiosa
- Musica classica e tradizionale non occidentale
- Musica per orchestra leggera e big band
- Musica per banda, musica militare e marce
- Musica folk e tradizionale
- Jazz
- Blues
- Musica country e western
- Musical
- Easy listening, MOR (musica di facile ascolto)
- Rock e pop
- Soul e rythm 'n' blues
- Rap e hip-hop
- Reggae
- Heavy metal
- Punk, new-wave e indie
- Musica elettronica
- World music
- Musica ambient e new age
- Singoli compositori, musicisti, band e gruppi musicali
- Partiture, spartiti, parole e libretti musicali
- Raccolte di canzoni
- Strumenti musicali e insiemi strumentali
- Orchestre
- Strumenti a tastiera
- Strumenti a percussione
- Strumenti a corda
- Chitarra
- Strumenti a fiato
- Strumenti musicali meccanici
- Strumenti musicali elettronici
- Tecniche musicali / apprendimento della musica
- Registrazione e riproduzione della musica
- BIOGRAFIE GENERALI
- Autobiografie generali
- Biografie: imprenditori e industriali
- Autobiografie: imprenditori e industriali
- Biografie: artisti e personalità dello spettacolo
- Autobiografie: artisti e personalità dello spettacolo
- Biografie: personaggi storici, politici e militari
- Autobiografie: personaggi storici, politici e militari
- Biografie: letterati
- Autobiografie: letterati
- Biografie: esponenti di case reali
- Autobiografie: esponenti di case reali
- Biografie: sportivi
- Autobiografie: sportivi
- Biografie: scienziati, tecnologi, ingegneri
- Autobiografie: scienziati, tecnologi, ingegneri
- Biografie: figure religiose e spirituali
- Autobiografie: figure religiose e spirituali
- DIARI E LETTERE
- MEMORIE
- STORIE VERE
- LINGUA: ARGOMENTI E OPERE GENERALI
- Dizionari
- Dizionari bilingui e multilingui
- Thesauri
- Grammatica e uso della lingua: guide pratiche
- Guide per parlare in pubblico
- Scrittura creativa e guide per la scrittura creativa
- Guide per la scrittura di sceneggiature
- Guide per la scrittura e l'elaborazione dei testi
- Guide per la scrittura giornalistica
- Scrittura tecnica
- Lingua: opere storiche e generali
- LINGUISTICA
- Filosofia del linguaggio
- Sociolinguistica
- Alfabetizzazione
- Psicolinguistica
- Apprendimento della lingua
- Bilinguismo e multilinguismo
- Linguistica comparata e storica
- Dialetti, slang e gerghi
- Semantica
- Fonetica, fonologia
- Grammatica, sintassi
- Paleografia e storia della scrittura
- Sistemi di scrittura, alfabeti
- Lessicografia
- Traduzione e interpretazione
- Linguistica computazionale
- Linguaggio dei segni, Braille e altri sistemi di comunicazione linguistica
- INSEGNAMENTO E APPRENDIMENTO DELLE LINGUE (DIVERSI DA ELT)
- Insegnamento delle lingue: teorie e metodi
- Materiali e corsi per l'insegnamento e l'apprendimento delle lingue
- Grammatica e vocabolario
- Letture per l'apprendimento delle lingue
- Testi per l'autoapprendimento delle lingue
- Corsi di lingua audiovisivi e multimediali
- Apprendimento della lingua: competenze specifiche
- Pronuncia e lingua parlata
- Ascolto
- Lettura
- Scrittura
- POESIA
- LETTERATURA TEATRALE
- SAGGISTICA
- ANTOLOGIE (ESCLUSE LE ANTOLOGIE DI POESIE)
- LETTERATURA: STORIA E CRITICA
- Teoria della letteratura
- Letteratura, storia e critica: studi generali
- Letteratura, storia e critica: letteratura antica, classica e medievale
- Letteratura, storia e critica: letteratura dal 1500 al 1800
- Letteratura, storia e critica: letteratura dal 1800 al 1900
- Letteratura, storia e critica: letteratura dal 1900
- Letteratura, storia e critica: letteratura post-coloniale
- Letteratura, storia e critica: poesia e poeti
- Letteratura, storia e critica: letteratura teatrale e drammaturghi
- Shakespeare: studi e critica
- Letteratura, storia e critica: narrativa, romanzieri e scrittori di prosa
- Letteratura: opere di consultazione
- Letteratura: guide
- Letteratura per bambini e ragazzi, storia e critica: studi generali
- GIALLO E NOIR
- THRILLER, SUSPENSE
- AVVENTURA
- FANTASCIENZA
- FANTASY
- SAGHE
- ENCICLOPEDIE E OPERE DI CONSULTAZIONE
- Enciclopedie generali
- Opere di consultazione
- Dizionari biografici (who's who)
- Dizionari di citazioni
- Bibliografie, cataloghi, discografie
- Pubblicazioni in serie, periodici, raccolte di abstract, indici
- Repertori e indirizzari
- Annuari, almanacchi
- Opere geografiche di consultazione
- Atlanti mondiali e planisferi
- Dizionari ed elenchi geografici
- BIBLIOTECONOMIA E SCIENZA DELL'INFORMAZIONE
- Gestione della biblioteca, degli archivi e delle informazioni
- Automazione della biblioteca ed elaborazione dei dati
- Acquisizioni e sviluppo delle collezioni
- Catalogazione formale e semantica
- Servizi bibliotecari e informativi
- Servizi bibliotecari alla comunità e servizi esterni
- Immagazzinamento, mantenimento e conservazione delle collezioni
- MUSEI E MUSEOLOGIA
- RICERCA E INFORMAZIONE: ARGOMENTI D'INTERESSE GENERALE
- STUDI INTERDISCIPLINARI
- STORIA
- Storia: teoria e metodi
- Storiografia
- Storia generale e mondiale
- Storia regionale e nazionale
- Storia d'Europa
- Storia della Gran Bretagna e dell'Irlanda
- Storia d'Italia
- Storia dell'Asia
- Storia del Medio Oriente
- Storia dell'Africa
- Storia delle Americhe
- Storia dell'Australasia e del Pacifico
- Storia di altri territori
- Storia: dalla preistoria al presente
- Storia antica: fino al 500 d.C.
- Storia e civiltà classica
- Storia: dal 500 d.C. al 1450-1500 d.C.
- Storia medievale
- Storia moderna dal 1450-1500 al 1700
- Storia contemporanea dal 1700 al 1900
- Storia del 20. Secolo dal 1900 al 2000
- Storia postbellica del 20. Secolo: dal 1945 al 2000
- Storia del 21. Secolo: dal 2000
- Storia: specifici eventi e argomenti
- Storia culturale e sociale
- Storia orale
- Genealogia, araldica, nomi e onorificenze
- Industrializzazione e storia industriale
- Storia della Marina
- Geografia storica
- Carte e atlanti storici
- Colonialismo e imperialismo
- Indipendenza e liberazione nazionale, post-colonialismo
- Schiavitù e abolizione della schiavitù
- Rivoluzioni, sollevazioni, rivolte
- Rivoluzione francese
- Rivoluzione russa
- Guerra Fredda
- Genocidi e pulizia etnica
- Olocausto
- Storia militare
- Crociate
- Guerra d'Indipendenza Americana
- Guerre napoleoniche
- Guerra Civile Americana
- Guerra di Crimea
- Guerra Boera
- Prima Guerra Mondiale
- Guerra Civile Spagnola
- Seconda Guerra Mondiale
- Storia militare: guerre successive alla Seconda Guerra Mondiale
- Guerra di Corea
- Guerra del Vietnam
- Guerra del Golfo
- Guerra dell'Afghanistan (2001)
- Guerra dell'Iraq
- ARCHEOLOGIA
- Teoria dell'archeologia
- Archeologia per periodo e regione
- Archeologia preistorica
- Egittologia
- Archeologia biblica
- Archeologia greca e romana classica
- Archeologia medievale europea
- Archeologia del paesaggio
- Archeologia ambientale
- Archeologia subacquea
- Archeologia industriale
- Metodologia e tecniche dell'archeologia
- FILOSOFIA
- Storia della filosofia occidentale
- Filosofia occidentale antica: fino al 500 d.C.
- Filosofia occidentale del Medioevo e del Rinascimento: dal 500 al 1600
- Filosofia occidentale: dal 1600 al 1900
- Filosofia occidentale: Illuminismo
- Filosofia occidentale: dal 1900
- Fenomenologia ed esistenzialismo
- Filosofia analitica e positivismo logico
- Decostruzionismo, strutturalismo, post-strutturalismo
- Filosofia non occidentale
- Filosofia islamica e araba
- Filosofia orientale e indiana
- Filosofia: metafisica e ontologia
- Filosofia: epistemologia e teoria della conoscenza
- Filosofia: logica
- Filosofia della mente
- Filosofia: estetica
- Etica e filosofia morale
- Filosofia sociale e politica
- Filosofia: opere divulgative
- RELIGIONE E FEDE
- Religione: argomenti d'interesse generale
- Filosofia della religione
- Natura e esistenza di Dio
- Religioni comparate
- Rapporti tra religioni diverse
- Problemi e controversie religiose
- Etica religiosa
- Religione e politica
- Religione e scienza
- Fondamentalismo religioso
- Blasfemia, eresia, apostasia
- Intolleranza religiosa, persecuzioni e conflitti
- Storia delle religioni
- Cristianesimo
- Vicenda storica di Gesù
- Chiese e denominazioni cristiane
- Chiesa antica
- Storia della Chiesa
- Cattolicesimo romano, Chiesa cattolica romana
- Chiese ortodosse e orientali
- Protestantesimo e chiese protestanti
- Chiesa anglicana ed episcopale, Chiesa d'Inghilterra
- Chiese battiste
- Chiese calviniste, riformate e presbiteriane
- Chiese metodiste
- Chiese pentecostali
- Quaccheri (Società religiosa degli amici)
- Altre chiese evangeliche e non conformiste
- Bibbia
- Antico Testamento
- Nuovo Testamento
- Studi ed esegesi biblica
- Commentari biblici
- Concordanze bibliche
- Esegesi ed ermeneutica biblica
- Studi biblici per individui o piccoli gruppi
- Letture bibliche, selezioni e meditazioni
- Ecumenismo
- Liturgia cristiana, libri di preghiere e raccolte di inni
- Libri di preghiere cristiane
- Raccolte di inni cristiani
- Teologia cristiana
- Sermoni (omelie) cristiane
- Culto, riti e cerimonie cristiane
- Preghiera cristiana
- Spiritualità ed esperienza religiosa cristiana
- Spiritualità ed esperienza religiosa cristiana
- Misticismo cristiano
- Vita e pratica cristiana
- Sacramenti cristiani
- Istruzione cristiana
- Terapia psicologica cristiana
- Aspetti cristiani della sessualità, dei generi e delle relazioni
- Testimonianze personali cristiane e opere di ispirazione popolare
- Istituzioni e organizzazioni cristiane
- Leader cristiani e leadership cristiana
- Ministero e attività pastorale cristiana
- Pensiero e attività sociali cristiane
- Missione cristiana ed evangelizzazione
- Comunità e monachesimo cristiano
- Culti e sette cristiani e quasi cristiani
- Buddismo
- Culto, riti e cerimonie buddiste
- Vita e pratica buddista
- Testi sacri buddisti
- Buddismo tibetano
- Buddismo Zen
- Induismo
- Culto, riti e cerimonie induiste
- Vita e pratica induista
- Testi sacri induisti
- Islam
- Culto, riti e cerimonie islamiche
- Vita e pratica islamica
- Corano
- Teologia islamica
- Sufismo e misticismo islamico
- Ebraismo
- Culto, riti e cerimonie ebraici
- Vita e pratica ebraica
- Testi sacri ebraici
- Teologia ebraica
- Misticismo ebraico
- Altre religioni non cristiane
- Baha'I
- Giainismo
- Religioni orientali
- Confucianesimo
- Shintoismo
- Taoismo
- Religioni e mitologie antiche
- Religione e mitologia dell'antico Egitto
- Religione e mitologia celtica
- Religione Sikh
- Religioni tribali
- Zoroastrismo
- Aspetti delle religioni non-cristiane
- Teologia
- Critica ed esegesi dei testi sacri
- Materiale per la preghiera e il culto
- Culto, riti e cerimonie
- Preghiere
- Spiritualità ed esperienze religiose
- Misticismo
- Vita e pratica religiosa
- Terapia psicologica basata sulla religione
- Aspetti religiosi della sessualità, dei generi e delle relazioni
- Istituti e organizzazioni religiose
- Leader spirituali e religiosi
- Pensiero e attività pastorali e sociali religiose
- Comunità religiose e monastiche
- Fedi alternative
- Alternative umaniste e secolari alla religione
- Agnosticismo e ateismo
- Religioni e fedi eclettiche ed esoteriche
- Gnosticismo
- Teosofia e antroposofia
- Culti e sette contemporanee non cristiane o para-cristiane
- Spiritismo
- Studi sull'occulto
- Magia, alchimia e pensiero ermetico
- Stregoneria
- Satanismo e demonologia
- SOCIETÀ E CULTURA: ARGOMENTI D'INTERESSE GENERALE
- Studi culturali (Cultural studies)
- Cultura e società
- Cultura materiale
- Moda e società
- Cibo e società
- Storia delle idee
- Studi sui mezzi di comunicazione di massa
- Televisione e società
- Pubblicità e società
- Problemi e processi sociali
- Povertà e disoccupazione
- Senzatetto
- Impatto sociale delle calamità
- Carestia
- Rifugiati e asilo politico
- Violenza nella società
- Violenza sui minori
- Violenza e molestie sessuali
- Violenza domestica
- Disabilità: aspetti sociali
- Malattia e dipendenza: aspetti sociali
- Abuso di droghe e di altre sostanze: aspetti sociali
- HIV e AIDS: aspetti sociali
- Discriminazione sociale
- Femminismo e teoria femminista
- Correttezza politica
- Mobilità sociale
- Migrazioni, immigrazione, emigrazione
- Interazione sociale
- Previsioni sociali, studi sul futuro della società
- Previsioni sociali, studi sul futuro della societÃ
- Globalizzazione
- Consumismo
- Animali e società
- Credenze popolari e conoscenze controverse
- Teorie della cospirazione
- Folklore, proverbi, miti e leggende
- Truffe e inganni
- Problemi e controversie etiche
- Problemi etici: aborto e controllo delle nascite
- Problemi etici: pena di morte
- Problemi etici: censura
- Problemi etici: eutanasia e diritto alla morte
- Problemi etici: sviluppo scientifico e tecnologico
- Problemi etici: pornografia e oscenità
- Problemi etici: prostituzione e industria del sesso
- Gruppi sociali
- Classi sociali
- Comunità rurali
- Comunità urbane
- Studi sui generi, gruppi sociali secondo il genere
- Studi sui generi: donne
- Studi sui generi: uomini
- Studi sui generi: transessuali ed ermafroditismo
- Studi su gay e lesbiche
- Studi su lesbiche
- Studi su uomini gay
- Studi etnografici
- Minoranze etniche e multiculturalismo
- Studi etnici su neri e asiatici
- Studi etnici su ispanici e latinoamericani
- Popoli indigeni
- Gruppi sociali in base all'età
- Gruppi sociali in base all'età: bambini
- Gruppi sociali in base all'età: adolescenti
- Gruppi sociali in base all'età: adulti
- Gruppi sociali in base all'età: anziani
- Gruppi religiosi: aspetti sociali e culturali
- Studi sull'Ebraismo
- Studi sull'Islam
- Stili di vita alternativi
- Gruppi sociali: club e società
- Massoneria e società segrete
- SOCIOLOGIA E ANTROPOLOGIA
- Sociologia
- Teoria sociale
- Ricerche e statistiche sociali
- Popolazione e demografia
- Sociologia della nascita
- Sociologia della famiglia e delle relazioni parentali
- Sociologia delle relazioni sessuali
- Sociologia del lavoro e dell'impiego
- Sociologia dello sport e del tempo libero
- Sociologia dei costumi e delle tradizioni
- Sociologia della morte
- Antropologia
- Antropologia sociale e culturale, etnografia
- Antropologia fisica
- SERVIZI SOCIALI, ASSISTENZA SOCIALE E CRIMINOLOGIA
- Assistenza sociale e servizi sociali
- Assistenza sociale e sistemi di sussidio
- Assistenza sociale per i bambini
- Adozione e affidamento
- Assistenza agli anziani
- Assistenza ai malati mentali
- Lavori sociali
- Associazioni caritatevoli, servizi di volontariato e filantropia
- Servizi di consulenza e terapia psicologica
- Programmi di aiuto e soccorso
- Servizi d'emergenza
- Servizi di polizia e sicurezza
- Servizi antincendio
- Servizi di ambulanza e protezione civile
- Reati e criminologia
- Cause e prevenzione dei reati
- Investigazione
- Scienza forense
- Commercio e traffico di droga
- Reati di strada, reati commessi con armi da fuoco
- Reati commessi da persone giuridiche e reati dei colletti bianchi
- Criminalità organizzata
- Pene e punizione
- Prigioni
- Delinquenti
- Riabilitazione dei delinquenti
- Delinquenza minorile
- Sospensione della pena e affidamento ai servizi sociali
- PSICOLOGIA
- Teoria psicologica e scuole di pensiero
- Teoria psicoanalitica (psicologia freudiana)
- Psicologia analitica e junghiana
- Teoria comportamentale (Psicologia del comportamento)
- Psicologia umanistica
- Cognitivismo, teoria cognitiva
- Metodologia psicologica
- Test e valutazioni psicologiche
- Psicologia infantile e dell'età evolutiva
- Psicologia dell'invecchiamento
- Psicologia della famiglia
- Psicologia dei generi sessuali
- Psicologia sociale, di gruppo o collettiva
- Psicologia industriale e del lavoro
- Psicologia criminale e legale
- Psicologia sperimentale
- Psicologia fisiologica e neuropsicologia, biopsicologia
- Psicologia anormale
- Psicologia: emozioni
- Coscienza e psicologia cognitiva
- Apprendimento
- Memoria
- Intelligenza e ragionamento
- Percezione
- Io, Ego, identità, personalità
- Stati di coscienza
- Conscio e inconscio
- Sonno e sogni
- Ipnosi
- Stati indotti dall'assunzione di droghe
- Comportamento sessuale
- Studi parapsicologici
- EDUCAZIONE
- Filosofia e teoria dell'educazione
- Finalità morali e sociali dell'educazione
- Psicologia dell'educazione
- Didattica: strategie e linee di condotta dell'educazione
- Strategie per l'alfabetizzazione
- Strategie per l'educazione matematica
- Educazione inclusiva, inserimento educativo
- Educazione multiculturale
- Educazione: assistenza e consulenza agli studenti
- Bullismo e strategie di contrasto al bullismo
- Assenze ingiustificate e strategie contro le assenze
- Espulsione e dispersione scolastica
- Organizzazione e gestione dell'educazione
- Procedure di ammissione
- Pianificazione e sviluppo del curriculum
- Esami e valutazione
- Ispezione scolastica e preparazione alle ispezioni
- Finanziamento dell'educazione e finanze degli studenti
- Insegnanti
- Valutazione degli insegnanti
- Personale non docente e ausiliario
- Relazioni tra scuola e comunità e tra scuola e famiglia
- Dirigenti e consigli scolastici
- Studenti e organizzazioni studentesche
- Scuole
- Nidi, asili, scuole materne
- Scuole primarie e secondarie inferiori
- Scuole secondarie superiori
- Scuole indipendenti, educazione privata
- Scuole confessionali e religiose
- Educazione superiore
- Scuole per l'educazione avanzata
- Scuole per l'educazione superiore
- Università
- Formazione degli insegnanti
- Educazione degli adulti, formazione continua
- Educazione aperta, educazione a distanza, educazione a domicilio
- Orientamento professionale
- Formazione industriale e professionale
- Insegnamento a gruppi specifici e a persone con particolari esigenze
- Insegnamento a disabili fisici
- Insegnamento a non udenti
- Insegnamento a non vedenti
- Insegnamento a studenti con particolari difficoltà o esigenze di apprendimento
- Insegnamento a dislessici
- Insegnamento ad autistici
- Insegnamento a studenti con difficoltà emotive o comportamentali
- Insegnamento a studenti dotati
- Competenze e tecniche d'insegnamento
- Insegnamento di specifiche materie
- Risorse e materiale per l'insegnante per l'utilizzo in aula
- Attrezzature e tecnologia per l'insegnamento insegnamento tramite l'utilizzo de
- Attrezzature e tecnologia per l'insegnamento insegnamento tramite l'utilizzo del computer (CAL)
- Attività extra-scolastiche
- Gite scolastiche e visite guidate
- Tecniche di apprendimento e studio
- POLITICA E GOVERNO
- Scienza e teoria politica
- Sistemi politici comparati
- Ideologie politiche
- Anarchismo
- Marxismo e Comunismo
- Socialismo e ideologie democratiche di sinistra
- Liberalismo e ideologie democratiche di centro
- Conservatorismo e ideologie democratiche di destra
- Nazionalismo
- Fascismo e Nazismo
- Ideologie religiose e teocratiche
- Struttura e processi politici
- Costituzione: Governo e Stato
- Elezioni e referendum
- Leader politici e leadership
- Strutture politiche: democrazia
- Strutture politiche: totalitarismo e dittatura
- Partiti politici
- Manifesti politici
- Pubblica amministrazione
- Governo centrale
- Politiche del governo centrale
- Governo locale
- Politiche del governo locale
- Relazioni internazionali
- Diplomazia
- Negoziazione e controllo degli armamenti
- Spionaggio e servizi segreti
- Geopolitica
- Istituzioni internazionali
- Nazioni Unite e agenzie delle Nazioni Unite
- Unione Europea e istituzioni europee
- Controllo politico e libertà
- Diritti umani
- Diritti civili e cittadinanza
- Libertà d'informazione e di opinione
- Diritti territoriali
- Libertà religiosa, libertà di culto
- Pubblica opinione e sondaggi
- Campagne elettorali e pubblicità politica
- Propaganda politica
- Oppressione e persecuzione politica
- Attivismo politico
- Gruppi di pressione e lobbies
- Manifestazioni e movimenti di protesta
- Organizzazioni non governative (ONG)
- Sovversione politica
- Terrorismo, lotta armata
- Assassini politici
- Attacchi terroristici
- Gruppi e movimenti rivoluzionari
- Conflitti armati
- Corruzione politica
- GUERRA E DIFESA
- Teoria della guerra e scienza militare
- Forze di terra e impiego operativo
- Forze irregolari o di guerriglia e impiego operativo
- Forze navali e impiego operativo
- Forze aeree e impiego operativo
- Forze speciali e truppe scelte
- Amministrazione militare
- Ricerca strategica e pianificazione della difesa
- Spionaggio militare
- Tattiche militari
- Difesa civile
- Guerra e operazioni di difesa
- Battaglie e campagne
- Operazioni di mantenimento della pace
- Armi e attrezzature belliche
- Armi chimiche e biologiche
- Armi nucleari
- Veicoli militari
- Carri armati e veicoli militari di terra
- Imbarcazioni e navi militari
- Aerei militari
- Vita e istituzioni militari
- Uniformi e distintivi
- Memoriali e liste d'onore
- Altri argomenti riguardanti guerra e difesa
- Traffico d'armi
- Crimini di guerra
- Mercenari
- Prigionieri di guerra
- Veterani militari
- Abilità e manuali di combattimento e difesa
- ECONOMIA
- Economia: filosofia e teoria
- Macroeconomia
- Economia monetaria
- Microeconomia
- Commercio interno
- Economia dell'organizzazione industriale
- Economia del lavoro
- Occupazione e disoccupazione
- Crescita economica
- Econometria
- Statistica economica
- Previsioni economiche
- Economia comportamentale
- Economia internazionale
- Finanza internazionale
- Commercio internazionale
- Accordi commerciali
- Economia dello sviluppo
- Economia ambientale
- Economia politica
- Economia sanitaria
- Economia del welfare
- Sistemi e strutture economiche
- Economia urbana
- Crisi e disastri finanziari
- Storia economica
- FINANZA E CONTABILITÀ
- Contabilità
- Contabilità dei costi
- Contabilità finanziaria
- Gestione contabile e tenuta dei libri contabili
- Contabilità delle finanze pubbliche
- Relazioni e attestazioni finanziarie
- Contabilità: guide allo studio e alla preparazione degli esami
- Finanza
- Finanza pubblica
- Fisco
- Finanza aziendale
- Tecnica bancaria
- Credito e istituti di credito
- Investimenti e titoli
- Materie prime
- Valori di borsa, titoli
- Assicurazioni e studi attuariali
- Pensioni
- Proprietà immobiliari e beni immobili
- Credito e finanza: guide allo studio e alla preparazione degli esami
- AFFARI E GESTIONE (MANAGEMENT)
- Affari: argomenti generali
- Affari e gestione: guide allo studio e alla preparazione degli esami
- Strategia d'impresa
- Innovazione d'impresa
- Commercio elettronico: aspetti imprenditoriali
- Competizione economica
- Etica degli affari
- Imprenditorialità
- Affari internazionali
- Consulenze e garanzie d'impresa
- Gestione e tecniche di gestione
- Gestione: leadership e motivazione
- Gestione dei processi decisionali
- Gestione di progetti
- Certificazione di qualità (QA) e qualità totale (TQM)
- Gestione del tempo
- Gestione di specifiche aree
- Gestione finanziaria e del budget
- Gestione del personale e delle risorse umane
- Gestione delle informazioni
- Gestione dei beni immobili, delle proprietà e degli impianti
- Gestione della produzione e controllo della qualità
- Gestione della ricerca e dello sviluppo
- Gestione delle vendite e del marketing
- Gestione degli acquisti e delle forniture
- Gestione della distribuzione e dei magazzini, logistica
- Trattative d'affari
- Comunicazioni e presentazioni negli affari
- Matematica e sistemi applicati agli affari
- Responsabilità di impresa e corporate governance
- Consigli d'amministrazione e amministratori: ruoli e responsabilità
- Segreteria esecutiva d'impresa: ruolo e responsabilità
- Vendite e marketing
- Pubblicità
- Ricerche di mercato
- Pubbliche relazioni
- Servizi per i clienti
- Ricerca operazionale
- Teoria dell'organizzazione e del comportamento
- Proprietà e organizzazione delle imprese
- Acquisizioni, fusioni e acquisizioni di controllo
- Privatizzazioni
- Imprese in franchising
- Multinazionali
- Imprese di proprietà pubblica, nazionalizzazioni
- Monopoli
- Piccole imprese e imprese individuali
- Associazioni di imprese (joint venture)
- Imprese di proprietà dei lavoratori e cooperative
- Organizzazioni senza scopo di lucro
- Uffici e luoghi di lavoro
- Gestione degli uffici
- Competenze di segreteria e impiegatizie
- Modelli e pratiche di lavoro
- INDUSTRIA E STUDI INDUSTRIALI
- Industrie primarie
- Agricoltura e industrie affini
- Pesca e industrie affini
- Silvicoltura e industrie affini
- Industrie minerarie
- Industrie e servizi energetici
- Industrie del carbone e dei combustibili solidi
- Industrie del gas
- Industrie per la produzione dell'energia elettrica
- Centrali nucleari
- Industrie petrolifere
- Industrie dell'energia alternativa e rinnovabile
- Industrie dell'acqua
- Industrie manifatturiere
- Industrie chimiche
- Industrie tessili
- Industrie alimentari e affini
- Industria del tabacco
- Industrie manifatturiere ad alta tecnologia
- Industrie biotecnologiche
- Industrie degli armamenti
- Industrie farmaceutiche
- Industria automobilistica
- Industria navale
- Industria aeronautica
- Industrie dei trasporti
- Industrie dei trasporti su strada
- Industrie dei trasporti marittimi
- Industrie dei trasporti su rotaia
- Industrie aerospaziali e dei trasporti aerei
- Aeroporti
- Costruzioni e industria pesante
- Industria delle costruzioni
- Industrie del ferro, dell'acciaio e metallurgiche
- Industrie della distribuzione
- Settore della vendita al dettaglio
- Settore della vendita all'ingrosso
- Industrie dei servizi
- Industria turistica
- Industria alberghiera
- Industria dello sport e del tempo libero
- Servizi di sicurezza
- Servizi di sorveglianza
- Industria dei servizi finanziari
- Industrie della moda e dell'estetica
- Industrie dei media, dell'informazione e della comunicazione
- Industria cinematografica
- Industria radiotelevisiva
- Industria musicale
- Stampa e giornalismo
- Industria editoriale
- Industria tipografiche, reprografica e dell'imballaggio
- Industrie delle poste e delle telecomunicazioni
- Industrie informatiche (industrie dell'information technology)
- Industrie di Internet e del World Wide Web
- Industria pubblicitaria
- Pubblica amministrazione e settore pubblico
- Relazioni industriali e sicurezza
- Relazioni industriali
- Scioperi
- Sindacati
- Negoziazione e arbitrato industriale
- Sicurezza e salute del lavoro e dell'industria
- MATEMATICA
- Filosofia della matematica
- Fondamenti della matematica
- Logica matematica
- Teoria degli insiemi
- Sistemi numerici
- Matematica discreta
- Algebra
- Gruppi e teoria dei gruppi
- Teoria dei numeri
- Calcolo e analisi matematica
- Calcolo
- Analisi reale e funzioni di variabile reale
- Analisi complessa, variabili complesse
- Analisi funzionale e trasformate
- Calcolo differenziale ed equazioni differenziali
- Calcolo integrale ed equazioni integrali
- Analisi numerica
- Geometria
- Trigonometria
- Geometria euclidea
- Geometria non-euclidea
- Geometria differenziale e di Rieman
- Geometria analitica
- Geometria algebrica
- Geometria frattale
- Topologia
- Topologia algebrica
- Probabilità e statistica
- Ottimizzazione
- Teoria dei giochi
- Programmazione lineare
- Calcolo combinatorio e teoria dei grafi
- Matematica applicata
- Modelli matematici
- Stocastica
- Scienza non lineare
- Teoria del caos
- Storia della matematica
- SCIENZE: ARGOMENTI D'INTERESSE GENERALE
- Filosofia della scienza
- Nomenclatura e classificazione scientifica
- Norme scientifiche
- Misurazione e sistemi di misura
- Matematica per gli scienziati
- Applicazioni industriali della ricerca scientifica e innovazioni tecnologiche
- Scienze: finanziamenti e politica
- Attrezzature scientifiche e tecniche, strumenti di laboratorio
- Microscopia
- Impatto della scienza e della tecnologia sulla società
- Storia delle scienze
- Scienze: opere divulgative
- ASTRONOMIA, SPAZIO E TEMPO
- FISICA
- Meccanica
- Meccanica analitica
- Meccanica dei fluidi
- Suoni, vibrazioni e onde (acustica)
- Dinamica e statica
- Gravità
- Energia
- Stati della materia
- Fisica della materia condensata (liquidi e solidi)
- Fisica dei gas
- Fisica del plasma
- Termodinamica e calore
- Ottica (luce)
- Elettricità, magnetismo ed elettromagnetismo
- Fisica molecolare e atomica
- Fisica della struttura nucleare
- Fisica delle particelle e delle alte energie
- Fisica quantistica (meccanica dei quanti e teoria del campo quantico)
- Fisica della relatività
- Fisica statistica
- Fisica matematica
- Fisica applicata
- Astrofisica
- Fisica medica
- Geofisica
- Fisica atmosferica
- Biofisica
- CHIMICA
- Chimica analitica
- Cromatografia
- Risonanza magnetica
- Analisi spettrografica, chimica spettrografica, spettrometria di massa
- Chimica inorganica
- Chimica organica
- Chimica organometallica
- Chimica dei polimeri
- Chimica fisica
- Catalisi
- Elettrochimica e magnetochimica
- Chimica nucleare, fotochimica e radiazioni
- Chimica degli stati solidi
- Termochimica e chimica termodinamica
- Cristallografia
- Mineralogia e gemmologia
- BIOLOGIA, SCIENZE DELLA VITA
- Scienze della vita: argomenti d'interesse generale
- Bioetica
- Ecologia, biosfera
- Xenobiologia (esobiologia)
- Evoluzione
- Genetica (non medica)
- DNA e genoma
- Neuroscienze
- Biochimica
- Proteine
- Tossicologia (non medica)
- Enzimologia
- Biologia dello sviluppo
- Biologia molecolare
- Biologia cellulare (citologia)
- Microbiologia (non medica)
- Batteriologia (non medica)
- Parassitologia (non medica)
- Virologia
- Protozoi
- Idrobiologia
- Biologia delle acque dolci, limnologia
- Biologia marina
- Micologia (non medica), funghi
- Botanica e scienze delle piante
- Fisiologia delle piante
- Riproduzione e propagazione delle piante
- Patologia e malattie delle piante
- Ecologia delle piante
- Algologia, alghe e licheni
- Zoologia e scienze degli animali
- Fisiologia degli animali
- Riproduzione degli animali
- Patologie e malattie degli animali
- Comportamento degli animali
- Ecologia degli animali
- Zoologia degli invertebrati
- Molluschi
- Crostacei
- Aracnidi
- Insetti (entomologia)
- Zoologia dei vertebrati
- Pesci (ittiologia)
- Anfibi
- Rettili
- Uccelli (ornitologia)
- Zoologia dei mammiferi
- Mammiferi marini e di acqua dolce
- Primati
- Biologia umana e argomenti correlati
- Paleontologia umana (uomini preistorici)
- Antropologia medica
- SCIENZE DELLA TERRA
- Vulcanologia e sismologia
- Geologia e litosfera
- Scienza del suolo, sedimentologia
- Processi delle superfici geologiche (geomorfologia)
- Geologia storica
- Petrografia
- Stratigrafia
- Geochimica
- Geologia economica
- Idrografia e idrosfera
- Oceanografia (mari)
- Limnologia (acque dolci)
- Meteorologia e climatologia
- Paleontologia
- GEOGRAFIA
- Geografia e topografia fisica
- Zone aride, deserti
- Paludi, acquitrini
- Foreste, foreste pluviali
- Delta, estuari, regioni costiere
- Montagne
- Geografia umana
- Geografia economica
- Geografia politica
- Geografia regionale
- Biogeografia
- Esplorazioni e scoperte geografiche
- Carte geografiche specialistiche
- Cartografia, disegno di carte geografiche e proiezioni
- Sistemi di informazione geografica (GIS) e rilevazioni a distanza
- Geodesia e rilevamenti per mappe e carte geografiche
- AMBIENTE
- Ideologia e pensiero ambientalista
- Organizzazioni ambientaliste, conservazioniste e ecologiste
- Ecologia applicata
- Biodiversità
- Gestione del territorio e risorse naturali
- Siccità e fornitura di acqua
- Gestione dei rifiuti
- Conservazione dell'ambiente
- Conservazione della natura e degli habitat
- Specie a rischio ed estinzione delle specie
- Inquinamento e minacce per l'ambiente
- Deforestazione
- Riscaldamento globale, buco dell'ozono
- Problemi legati al nucleare
- Disastri naturali
- Sostenibilità
- Impatto sociale dei problemi ambientali
- PIANIFICAZIONE REGIONALE E DI AREA
- TECNOLOGIA: ARGOMENTI D'INTERESSE GENERALE
- Ingegneria: argomenti d'interesse generale
- Disegno tecnico
- Disegno tecnico computerizzato (CAD)
- Ergonomia
- Ingegneria grafica e disegno tecnico
- Matematica applicata all'ingegneria
- Strumenti e strumentazioni in ingegneria
- Sistemi di misura e calibrazione in ingegneria
- Nanotecnologie
- Storia dell'ingegneria e della tecnologia
- Invenzioni e inventori
- INGEGNERIA BIOCHIMICA
- CHIMICA INDUSTRIALE E TECNOLOGIE MANUFATTURIERE
- Chimica industriale
- Ingegneria chimica
- Tecnologia delle polveri
- Tecnologia degli insetticidi e degli erbicidi
- Tecnologia dei pigmenti, dei coloranti e delle pitture
- Tecnologia dei cosmetici
- Tecnologia dei rivestimenti di superfici
- Tecnologia della plastica e dei polimeri
- Tecnologia della ceramica e del vetro
- Tecnologie alimentari
- Tecnologia della fabbricazione della birra
- Tecnologia del vino
- Tecnologia farmaceutica
- Tecnologia del cuoio e delle pellicce
- Tecnologia dei tessuti e delle fibre tessili
- Lavorazione di legnami e legno
- Tecnologia della cellulosa e della carta
- Tecnologia dei metalli e metallurgia
- Altre tecnologie manifatturiere
- Manifattura di strumenti di precisione
- Orologi e cronometri (orologeria)
- Manifattura degli elettrodomestici
- Manifattura dei mobili e degli accessori di arredamento
- Manifattura di abbigliamento e calzature
- Tecnologia della stampa e della riproduzione
- INGEGNERIA MECCANICA E MATERIALI
- Ingegneria meccanica
- Tribologia (frizione e lubrificazione)
- Motori e trasmissione di potenza
- Motori a vapore
- Scienza dei materiali
- Ingegneria termodinamica
- Meccanica dei solidi
- Dinamica e vibrazioni
- Meccanica dei fluidi
- Aerodinamica
- Idraulica e pneumatica
- Flusso, turbolenza, reologia
- Test non distruttivi
- Ingegneria di produzione
- Manifattura computerizzata (CAM)
- Controllo di qualità
- Ingegneria dell'affidabilità
- Ingegneria: professioni e competenze
- Costruzione di utensili
- Saldatura
- ENERGIA: TECNOLOGIA E INGEGNERIA
- Tecnologie dei combustibili fossili
- Tecnologia del gas naturale
- Tecnologia del petrolio
- Tecnologia dei combustibili solidi
- Energia e ingegneria nucleare
- Processi di conduzione del calore
- Ingegneria elettrica
- Produzione e distribuzione dell'energia elettrica
- Reti, sistemi, stazioni e impianti energetici
- Utilizzo e applicazioni dell'energia elettrica
- Trasformazione e immagazzinamento dell'energia
- Motori elettrici
- Energia elettrica: professioni e competenze
- Fonti e tecnologie di energia alternativa e rinnovabile
- INGEGNERIA ELETTRONICA E DELLE COMUNICAZIONI
- Ingegneria elettronica
- Circuiti e componenti
- Materiali e dispositivi elettrici
- Microprocessori
- Semi-conduttori e superconduttori
- Ingegneria del controllo automatico
- Robotica
- Tecnologia delle microonde
- Telecomunicazioni e Ingegneria delle comunicazioni
- Radar
- Radiotecnica
- Comunicazione satellitare
- Tecnologia telefonica
- Tecnologia dei telefoni mobili
- Tecnologia televisiva
- Tecnologia WAP (wireless)
- INGEGNERIA CIVILE, TOPOGRAFIA E COSTRUZIONI
- Ingegneria strutturale
- Rilevamenti
- Meccanica del suolo e delle rocce
- Ingegneria dei terremoti
- Ponti
- Ingegneria idraulica
- Dighe e bacini
- Porti
- Controllo delle inondazioni
- Bonifica del suolo e drenaggio
- Ingegneria stradale e del traffico
- Edilizia e materiali
- Prevenzione e sicurezza antincendio
- Riscaldamento, illuminazione e ventilazione
- Sistemi d'allarme e allarmi antincendio
- Conservazione degli edifici e materiali da costruzione
- Edilizia: professioni e competenze
- Muratura
- Carpenteria
- Idraulica (edilizia)
- Costruzione di tetti
- SCIENZA, INGEGNERIA E TECNOLOGIA AMBIENTALE
- TECNOLOGIA E PROFESSIONI DEI TRASPORTI
- Tecnologia e professioni automobilistiche
- Meccanica automobilistica e motoristica: professioni e competenze
- Professionalità relative ai trasporti stradali
- Tecnologia, ingegneria e professioni relative alle ferrovie
- Trasporti su rotaia: professioni e competenze
- Tecnologia e ingegneria navale
- Architettura navale
- Navigazione e nautica
- Nautica e trasporti marittimi: professioni e competenze
- Tecnologia aerospaziale e aerea
- Aviazione e pilotaggio: professioni e competenze
- Tecnologia dei sistemi di trasporto intelligenti e automatizzati
- ALTRE TECNOLOGIE
- Ingegneria acustica e ingegneria del suono
- Ottica applicata
- Fibre ottiche
- Tecnologia laser e olografia
- Sistemi e tecnologie di ripresa delle immagini
- Sistemi e tecnologie di scansione
- Scienze spaziali
- Astronautica
- Ingegneria militare
- Artiglieria e tecnologia degli armamenti
- Tecnologia degli esplosivi e pirotecnica
- Ingegneria marina
- Tecnologia e ingegneria mineraria
- Altre professioni e competenze in ambito tecnologico
- Alberghi e ristorazione: professioni e competenze
- Parrucchieri e saloni di bellezza
- Professioni e competenze in ambito rurale
- AGRICOLTURA E ALLEVAMENTO
- Scienze agrarie
- Ingegneria e macchinari agrari
- Irrigazione
- Agricoltura sostenibile
- Coltivazioni biologiche
- Allevamento di animali
- Nutrizione degli animali
- Produzione casearia
- Apicoltura
- Avicoltura
- Agronomia e produzione
- Coltivazione dei cereali
- Fertilizzanti e concimi
- Aziende agricole di piccole dimensioni
- Controllo degli infestanti
- Agricoltura tropicale: pratica e tecniche
- Scienze forestali e silvicoltura: pratica e tecniche
- Orticoltura
- Viticoltura
- Acquacoltura e allevamenti ittici: pratica e tecniche
- FAMIGLIA E SALUTE
- Sicurezza domestica
- Medicina e salute: opere divulgative
- Primo soccorso domestico
- Salute degli uomini
- Salute delle donne
- Assistenza e cura infermieristica domestica
- Problemi personali
- Malattia
- Disabilità
- Vecchiaia
- Disordini alimentari
- Droga e alcolismo
- Ansia e fobie
- Stress
- Morte e lutto
- Smettere di fumare
- Forma fisica e dieta
- Diete e dietologia
- Esercizio fisico e allenamento
- Massaggi
- Famiglia e relazioni interpersonali
- Sesso, sessualità e manuali per il sesso
- Corteggiamento, relazioni, convivenza e matrimonio
- Adozione
- Separazione e divorzio
- Relazioni intergenerazionali
- Consigli per l'educazione dei figli
- Gravidanza, parto e puericultura
- Nomi da dare ai bambini
- Cura e allevamento dei bambini
- Adolescenti: consigli per i genitori
- AUTO AIUTO E VALORIZZAZIONE PERSONALE
- Finanza personale
- Consigli sulle professioni e sul raggiungimento del successo
- Diritto per lettori non specialisti
- Codice della strada e comportamento stradale
- Consigli per i consumatori
- Proprietà immobiliare per i privati: compravendita e aspetti legali
- Consigli sull'educazione
- Guide e manuali per l'alfabetizzazione degli adulti
- Guide e manuali per l'educazione matematica degli adulti
- Psicologia: opere divulgative
- Assertività, motivazione e autostima
- Assertività , motivazione e autostima
- Tecniche di miglioramento della memoria e del pensiero
- Programmazione neurolinguistica (PNL)
- Pensionamento
- Vivere e lavorare all'estero
- Autosufficienza
- MENTE, CORPO E SPIRITO
- Mente, corpo e spirito: pensiero e pratica
- Predizione del futuro e divinazione
- Astrologia
- Segni zodiacali e oroscopi
- Cartomanzia
- Tarocchi
- I Ching
- Grafologia
- Chiromanzia, frenologia e fisiognomica
- Numerologia
- Chiaroveggenza e precognizione
- Terapie e medicina alternativa
- Tecnica Alexander
- Aromaterapia e oli essenziali
- Omeopatia
- Riflessologia
- Reiki
- Medicina tradizionale e rimedi erboristici
- Medicina cinese e agopuntura
- Terapie ayurvediche
- Mente, corpo, spirito: meditazione e focalizzazione
- Sogni e interpretazione dei sogni
- Poteri e fenomeni psichici
- Cristalloterapia e cromoterapia
- Chakra, aura e poteri spirituali
- Proiezione astrale ed esperienze extracorporee
- Reincarnazione e vite passate
- Spiriti guida, angeli e medianità
- Fenomeni inspiegabili e paranormale
- UFO ed extraterrestri
- Fantasmi e poltergaist
- Mostri ed esseri leggendari
- Feng Shui
- Misticismo, magia e rituali
- Kabbalah (Cabala): opere popolari
- Magia, formule magiche e alchimia
- Sciamanesimo, paganesimo e druidismo
- Stregoneria e wicca
- CUCINA, CIBI, BEVANDE E ARGOMENTI CORRELATI
- Cucina: opere e ricette generali
- Cucina di cuochi celebri e della televisione
- Cucina per single
- Cucina facile e veloce
- Cucina salutista e integrale
- Cucina per specifiche diete e regimi alimentari
- Cucina vegetariana
- Cucina nazionale e regionale
- Cucina per i bambini e con i bambini
- Cucina per le feste
- Cucina con specifici attrezzi
- Cucina con specifici ingredienti
- Cucina: carne e selvaggina
- Cucina: pollo e carni bianche
- Cucina: pesce e frutti di mare
- Cucina: erbe e spezie
- Cucina: pasta
- Cucina: latte e latticini
- Cucina: cioccolato
- Cucina: piatti e portate
- Minestre e primi piatti
- Insalate
- Secondi piatti
- Dolci e dessert
- Torte, dolci da forno, gelati e decorazioni con lo zucchero
- Conservazione e congelazione
- Bevande
- Bevande alcoliche
- Vini
- Birre
- Liquori e cocktail
- Bevande analcoliche
- Sigari e fumo
- ANTICHITÀ E COLLEZIONI
- ANTICHITÀ E COLLEZIONI
- Antichità e collezioni: guide all'acquisto
- Conservazione e restauro delle antichità
- Monete, banconote, medaglie, sigilli (numismatica)
- Francobolli, filatelia
- Orologi, scatole musicali e automi meccanici
- Oggetti militari, armi e armature
- Mobili antichi, collezioni di mobili
- Antichità e collezioni: ceramica e vetro
- Antichità e collezioni: gioielli
- Antichità e collezioni: oggetti in oro e argento diversi dai gioielli
- Antichità e collezioni: libri, manoscritti, opuscoli, materiale a stampa
- Antichità e collezioni: quadri, stampe, mappe
- Antichità e collezioni: tappeti, arazzi e tessuti
- Antichità e collezioni: giocattoli, giochi e modellini
- Antichità e collezioni: giocattoli, giochi e modellini
- Antichità e collezioni: strumenti scientifici e musicali
- HOBBY, QUIZ E GIOCHI
- ARTIGIANATO E ARTI DECORATIVE
- Manuali di arte e pittura
- Cucito e lavori con tessuto
- Ricamo
- Pizzi e lavori all'uncinetto
- Trapunte, patchwork e applicazioni
- Lavori a maglia e crochet
- Batik e tie-dye
- Lavori in corda, nodi e macramè
- Tappeti
- Filatura e tessitura meccanica
- Giocattoli: creazione e decorazione
- Creazione di gioielli e collane
- Finiture e superfici decorative
- Lavori decorativi in legno e metallo
- Cornici
- Lavori in terracotta, ceramica, vetro
- Incisione, modellazione e colatura in stampo
- Creazione di libri e lavori con la carta
- Cartoline
- Origami e costruzioni con la carta
- Lettering e calligrafia
- Artigianato rurale
- Composizioni floreali e arte floreale
- TRASPORTI: ARGOMENTI D'INTERESSE GENERALE
- Veicoli stradali a motore: argomenti d'interesse generale
- Autoveicoli: argomenti d'interesse generale
- Bus, tram e veicoli commerciali: argomenti d'interesse generale
- Motocicli: argomenti d'interesse generale
- Trattori e veicoli rurali: argomenti d'interesse generale
- Manutenzione dei veicoli
- Treni e trasporti su rotaie: argomenti d'interesse generale
- Navi e barche: argomenti d'interesse generale
- Stretti e canali
- Aerei: argomenti d'interesse generale
- UMORISMO
- GUIDE ALLO STILE DI VITA E ALLO STILE PERSONALE
- MANUTENZIONE DELLA CASA
- GIARDINAGGIO
- Giardini (descrizione, storia, ecc.)
- Progettazione e design del giardino
- Serre, patii
- Giardinaggio: piante
- Giardinaggio: fiori
- Giardinaggio: frutta e verdura
- Giardinaggio: erbe
- Piante grasse e cactus
- Giardinaggio: arbusti e alberi
- Piante da interno
- Tecniche specifiche di giardinaggio
- Bonsai
- Giardinaggio biologico
- Giardinaggio paesaggistico
- Giardinaggio naturale e selvatico
- Giardinaggio con piante autoctone
- Giardinaggio di piante in vaso
- Giardini acquatici, laghetti
- Orti
- NATURA, VITA IN CAMPAGNA E ANIMALI DOMESTICI
- Dinosauri e animali preistorici
- Animali selvatici: argomenti d'interesse generale
- Animali selvatici: volatili e birdwatching
- Animali selvatici: mammiferi
- Animali selvatici: rettili e anfibi
- Animali selvatici: farfalle, altri insetti e ragni
- Animali selvatici: animali acquatici
- Animali marini e costieri
- Animali d'acqua dolce
- Campagna, vita in campagna
- Animali della fattoria e da lavoro
- Animali domestici e da compagnia
- Animali domestici: gatti
- Animali domestici: cani
- Addestramento e allenamento dei cani
- Pesci e acquari
- Cavalli e pony
- Animali domestici: uccelli, inclusi uccelli da gabbia
- Animali domestici: conigli e roditori
- Animali domestici: rettili e anfibi
- Animali domestici: insetti e ragni
- Zoo e parchi naturali
- Alberi, fiori e piante selvatiche
- Rocce, minerali e fossili
- Terra: storia naturale generale
- Tempo atmosferico
- Astronomia e spazio: opere divulgative
- INTERESSE LOCALE, STORIA FAMILIARE, RICORDI
- SPORT E VITA ALL'APERTO
- Rugby league (rugby a 13)
- Rugby union (rugby a 15)
- Rugby
- Calcio
- Eventi sportivi, tour e organizzazioni
- Giochi olimpici
- Enti di governo dello sport
- Squadre e club sportivi
- Sedi per incontri sportivi
- Allenamenti sportivi
- Psicologia dello sport
- Abuso di farmaci nello sport (doping)
- Sport estremi
- Sport e spettacoli aeronautici
- Giochi con la palla
- Coppa del mondo di calcio
- Cricket
- Golf
- Hockey
- Pallacanestro
- Football australiano
- Giochi con la racchetta
- Tennis
- Volano
- Squash e rackets (racquets)
- Ping pong (tennis da tavolo)
- Football americano
- Baseball
- Pallavolo
- Bowling, bocce, petanque
- Snooker, biliardo, biliardo americano (pool)
- Atletica e sport da campo e da pista
- Maratona e corsa campestre
- Sport multidisciplinari
- Ginnastica
- Sollevamento pesi
- Sport equestri e con gli animali
- Corse dei cavalli
- Equitazione e salto ostacoli
- Sport motoristici
- Corse automobilistiche
- Formula 1 e gran premi
- Rally e guida rally
- Corse motociclistiche
- Ciclismo e mountain bike
- Pattini a rotelle, skatebord ecc.
- Sport e divertimenti acquatici
- Nuoto e immersioni
- Nuoto subacqueo
- Surf, windsurf e sci d'acqua
- Nautica
- Barche a motore ed elettriche
- Barche a vela
- Canoa e kayak
- Canottaggio
- Combattimento e difesa personale
- Boxe
- Lotta e Wrestling
- Scherma
- Arti marziali
- Bodybuilding
- Sport invernali
- Sci
- Snowboard
- Pattinaggio su ghiaccio
- Hockey su ghiaccio
- Sport all'aria aperta: pesca, caccia, tiro a segno
- Pesca
- Caccia
- Tiro con l'arco
- Piccole armi da fuoco, pistole e altra attrezzatura
- Tiro al bersaglio
- Attività sportive all'aperto
- Passeggiate, escursioni, trekking
- Alpinismo, arrampicate e scalate
- Orienteering
- Esplorazione di caverne e speleologia
- Campeggio e escursioni nei boschi
- Sopravvivenza
- VIAGGI E VACANZE
- Consigli e suggerimenti per i viaggiatori: argomenti d'interesse generale
- Guide ai viaggi e alle vacanze
- Viaggi avventura
- Viaggi d'affari
- Guide eco-turistiche
- Viaggi con i bambini, viaggi per la famiglia
- Guide agli alberghi e all'alloggio
- Guide ai campeggi
- Guide a musei, siti storici, gallerie e siti artistici
- Guide a ristoranti, caffè, pub
- Parchi a tema e lunapark
- Crociere
- Dizionari fraseologici
- Letteratura di viaggio
- Letteratura di viaggio classica
- Resoconti di esplorazioni, imprese, spedizioni
- Luoghi e popoli: opere illustrate
- Carte e atlanti geografici
- Atlanti stradali
- Carte geografiche
- Mappe stradali e piante di città
- MISCELLANEA
- Nessuna categoria
- NARRATIVA
- NARRATIVA CLASSICA (PRIMA DEL 1945)
- NARRATIVA MODERNA E CONTEMPORANEA (DOPO IL 1945)
- NARRATIVA DI ARGOMENTO MITOLOGICO
- NARRATIVA DI ARGOMENTO RELIGIOSO E SPIRITUALE
- NARRATIVA: SPECIFICI TEMI E ARGOMENTI
- NARRATIVA: ARGOMENTI CORRELATI
- NARRATIVA HORROR E GOTICA
- NARRATIVA EROTICA
- NARRATIVA ROSA
- NARRATIVA DI AMBIENTAZIONE STORICA
- NARRATIVA A FUMETTI
- BAMBINI E RAGAZZI
- POESIA, ANTOLOGIE, ANNUARI PER BAMBINI E RAGAZZI
- LIBRI ILLUSTRATI, LIBRI DI ATTIVITÀ, E MATERIALE PER L'APPRENDIMENTO PRECOCE
- Libri illustrati
- Libri per la prima infanzia
- Libri illustrati: libri con personaggi
- Fiabe e storie illustrate
- Libri e materiali interattivi e di attività
- Libri e materiali interattivi e di attivitÃ
- Libri da colorare e dipingere
- Libri da costruire
- Libri pop-up e con finestre
- Libri con adesivi
- Libri gioco e libri sagomati
- Storie con suoni, libri musicali e libri con rumori
- Libri tattili
- Libri magnetici
- Libri puzzle
- Primo apprendimento
- Primo apprendimento: alfabeto
- Primo apprendimento: prime parole
- Primo apprendimento: rime e giochi di parole
- Primo apprendimento: poesie e filastrocche
- Primo apprendimento: numeri e calcoli
- Primo apprendimento: colori
- Primo apprendimento: contrari
- Primo apprendimento: grandezze, forme e modelli
- Primo apprendimento: tempo e stagioni
- Primo apprendimento: ore, orario
- Primo apprendimento: prime esperienze
- Primo apprendimento: i cinque sensi
- NARRATIVA E STORIE VERE PER BAMBINI E RAGAZZI
- Narrativa classica (bambini e ragazzi)
- Narrativa generale (bambini e ragazzi)
- Avventura (bambini e ragazzi)
- Thriller (bambini e ragazzi)
- Giallo e mystery (bambini e ragazzi)
- Narrativa horror e del terrore, storie di fantasmi (bambini e ragazzi)
- Fantascienza (bambini e ragazzi)
- Fantasy e realismo magico (bambini e ragazzi)
- Storie tradizionali, miti, mitologia (bambini e ragazzi)
- Narrativa d'amore (bambini e ragazzi)
- Narrativa sulla famiglia e la casa (bambini e ragazzi)
- Narrativa di animali (bambini e ragazzi)
- Narrativa umoristica (bambini e ragazzi)
- Narrativa sportiva (bambini e ragazzi)
- Narrativa ambientata nella scuola (bambini e ragazzi)
- Narrativa storica (bambini e ragazzi)
- Racconti e storie brevi (bambini e ragazzi)
- Narrativa a fumetti, strisce a fumenti (bambini e ragazzi)
- Storie vere (bambini e ragazzi)
- NON FICTION PER BAMBINI E RAGAZZI
- Arte: argomenti d'interesse generale (bambini e ragazzi)
- Rugby (bambini e ragazzi)
- Musica: argomenti d'interesse generale (bambini e ragazzi)
- Musica leggera (bambini e ragazzi)
- Teatro e spettacolo (bambini e ragazzi)
- Danza, balletto (bambini e ragazzi)
- Testi teatrali (bambini e ragazzi)
- Televisione e cinema (bambini e ragazzi)
- Cultura generale e curiosità (bambini e ragazzi)
- Biblioteche, musei, scuole (bambini e ragazzi)
- Storia e passato: argomenti d'interesse generale (bambini e ragazzi)
- Guerra, battaglie, forze armate (bambini e ragazzi)
- Lavoro e industria, mondo del lavoro (bambini e ragazzi)
- Persone e luoghi (bambini e ragazzi)
- Natura (bambini e ragazzi)
- Dinosauri e mondo preistorico (bambini e ragazzi)
- Animali domestici (bambini e ragazzi)
- Animali della fattoria (bambini e ragazzi)
- Animali selvaggi (bambini e ragazzi)
- Interessi pratici (bambini e ragazzi)
- Cucina e cibo (bambini e ragazzi)
- Giardinaggio (bambini e ragazzi)
- Attività manuali (bambini e ragazzi)
- Denaro (bambini e ragazzi)
- Religioni e fedi: argomenti d'interesse generale (bambini e ragazzi)
- Bibbia e storie bibliche (bambini e ragazzi)
- Scienza e tecnologia: argomenti d'interesse generale (bambini e ragazzi)
- Edifici e costruzioni (bambini e ragazzi)
- Trasporti (bambini e ragazzi)
- Spazio (bambini e ragazzi)
- Umorismo e barzellette (bambini e ragazzi)
- Cartoni animati e fumetti (bambini e ragazzi)
- Hobby, quiz e giochi (bambini e ragazzi)
- Enigmistica (bambini e ragazzi)
- Guide ai videogiochi (bambini e ragazzi)
- Sport e attività all'aria aperta (bambini e ragazzi)
- Calcio (bambini e ragazzi)
- Atletica e ginnastica (bambini e ragazzi)
- Nuoto e sport acquatici (bambini e ragazzi)
- Ciclismo, skateboard e pattinaggio (bambini e ragazzi)
- Misteri e soprannaturale (bambini e ragazzi)
- UFO ed extraterrestri (bambini e ragazzi)
- Streghe e fantasmi (bambini e ragazzi)
- MATERIALE EDUCATIVO
- Materiale educativo: musica
- Materiale educativo: lingue straniere
- Materiale educativo: geografia
- Materiale educativo: storia
- Materiale educativo: lingua italiana
- Materiale educativo: letteratura italiana
- Edizioni scolastiche di testi di narrativa
- Materiale educativo: matematica e aritmetica
- Materiale educativo: educazione civica e sociale
- Materiale educativo: religione
- Materiale educativo: religione: cristianesimo
- Materiale educativo: scienze, argomenti scientifici generali
- Materiale educativo: fisica
- Materiale educativo: tecnologia
- Materiale educativo: tecnologie alimentari
- Materiale educativo: informatica, computer, telecomunicazioni
- Materiale educativo: economia
- Materiale educativo: guide allo studio e alla preparazione degli esami
- MATERIALE DI CONSULTAZIONE PER BAMBINI E RAGAZZI
- TEMI PERSONALI E SOCIALI
- Temi personali e sociali: corpo e salute (bambini e ragazzi)
- Temi personali e sociali: educazione sessuale e ai fatti della vita (bambini e r
- Temi personali e sociali: educazione sessuale e ai fatti della vita (bambini e ragazzi)
- Temi personali e sociali: bullismo, violenza, molestie (bambini e ragazzi)
- Temi personali e sociali: problemi familiari (bambini e ragazzi)
- Temi personali e sociali: divorzio, separazione e disgregazione della famiglia (
- Temi personali e sociali: divorzio, separazione e disgregazione della famiglia (bambini e ragazzi)
- Temi personali e sociali: droghe e dipendenza (bambini e ragazzi)
- Temi personali e sociali: disabilità e particolari necessità (bambini e ragazzi)
- Temi personali e sociali: autocoscienza e autostima (bambini e ragazzi)
- Temi personali e sociali: razzismo e multiculturalismo (bambini e ragazzi)
- Temi personali e sociali: sessualità e relazioni (bambini e ragazzi)
- Temi personali e sociali: assenteismo e problemi scolastici (bambini e ragazzi)
- Temi sociali (bambini e ragazzi)
- Temi sociali: ambiente e problemi ambientali (bambini e ragazzi)
- Temi sociali: religioni (bambini e ragazzi)
- Temi sociali: guerre e conflitti (bambini e ragazzi)
- ARTICOLI DI CANCELLERIA E OGGETTI MISCELLANEI PER BAMBINI
- INFORMATICA
- INFORMATICA: ARGOMENTI D'INTERESSE GENERALE
- SISTEMI DIGITALI PER LA VITA QUOTIDIANA
- Guide a Internet e servizi online
- Commercio elettronico e aste online
- Ricerche in Internet
- Gioco d'azzardo su Internet
- Finanza e investimenti su Internet
- Browser Internet
- Posta elettronica: guide per gli utenti e i consumatori
- Computer palmari e altri dispositivi portatili: guide per gli utenti e i consuma
- Computer palmari e altri dispositivi portatili: guide per gli utenti e i consumatori
- Musica digitale: guide per gli utenti e i consumatori
- Fotografia digitale: guide per gli utenti e i consumatori
- Video digitale: guide per gli utenti e i consumatori
- Telefoni cellulari: guide per gli utenti e i consumatori
- Televisione digitale e dispositivi multimediali: guide per gli utenti e i consum
- Videogiochi: guide strategiche
- APPLICAZIONI PROFESSIONALI
- Pacchetti software integrati
- Microsoft Office
- OpenOffice
- iWork
- Fogli di calcolo
- Excel
- Lotus 1-2-3
- Programmi per l'elaborazione di testi
- Microsoft Word
- Programmi per presentazioni grafiche
- PowerPoint
- Programmi di contabilità
- Programmi per la gestione d'impresa
- SAP (sistemi, applicazioni e prodotti di database)
- Programmi matematici e statistici
- Programmi per la gestione di progetti
- APPLICAZIONI GRAFICHE E MULTIMEDIALI
- Grafica e web-design
- Disegno tecnico computerizzato (CAD)
- Impaginazione
- Programmi per la realizzazione di videogiochi
- Grafica e modellazione 3D
- Programmi di illustrazione e grafica
- Musica digitale: argomenti professionali
- Animazione digitale
- Elaborazione di fotografie e immagini
- Video digitale: argomenti professionali
- HARDWARE
- SISTEMI OPERATIVI
- PROGRAMMAZIONE E SVILUPPO DEL SOFTWARE
- Teoria e apprendimento della programmazione
- Algoritmi e strutture di dati
- Compilatori
- Programmazione Agile
- Programmazione funzionale
- Sviluppo e programmazione di videogiochi
- Programmazione di videogiochi: grafica 2D
- Programmazione grafica
- Programmazione a oggetti (OOP)
- Programmazione Microsoft
- Programmazione .Net (Dot Net)
- Programmazione Windows
- Programmazione Macintosh
- Programmazione di reti
- Programmazione di computer palmari
- Programmazione di database
- Programmazione Web
- Web services
- Linguaggi di programmazione: argomenti d'interesse generale
- Ingegneria del software
- Linguaggio UML (Unified Modeling Language)
- Test e verifica del software
- Progettazione del software orientata agli oggetti
- DATABASE
- CERTIFICAZIONE INFORMATICA
- COMUNICAZIONE TRA COMPUTER E RETI
- SCIENZA DEI CALCOLATORI
- Teoria matematica dei calcolatori
- Matematica applicata all'informatica
- Sistemi di analisi e progettazione
- Architettura dei calcolatori e progettazione logica
- Linguaggi di assemblaggio
- Intelligenza artificiale
- Sistemi esperti e knowledge-based
- Linguaggio naturale e traduzione automatica
- Apprendimento automatico (Machine learning)
- Reti neurali e sistemi fuzzy
- Elaborazione dei segnali
- Elaborazione delle immagini
- Realtà virtuale
- Interazione uomo-macchina
- Visualizzazione delle informazioni
- Progettazione di interfacce utente e usabilità
- Architettura delle informazioni
- MEDICINA
- MEDICINA GENERALE
- Professione medica
- Etica medica e condotta professionale
- Relazioni medico-paziente
- Attrezzature e tecniche mediche
- Tecniche e analisi mediche di laboratorio
- Ricerca medica
- Sperimentazioni cliniche
- Telemedicina
- Salute pubblica e medicina preventiva
- Esami medici
- Salute personale e pubblica
- Igiene
- Fattori ambientali
- Dietetica e nutrizione
- Controllo delle nascite, contraccezione e pianificazione familiare
- Psicologia sanitaria
- Epidemiologia e statistica medica
- Servizi e sistemi sanitari
- Pratica medica generale
- Servizi per la salute mentale
- Amministrazione e gestione ospedaliera
- Assicurazioni sanitarie
- Argomenti medico-legali
- Sociologia della medicina
- Storia della medicina
- MEDICINA PRE-CLINICA: SCIENZE DI BASE
- CLINICA E MEDICINA INTERNA
- Diagnostica medica
- Esame del paziente
- Malattie e disturbi
- Malattie e disturbi congeniti
- Malattie e disturbi ereditari
- Malattie infettive e contagiose
- Malattie veneree
- HIV e AIDS
- Infezioni ospedaliere
- Oncologia
- Radioterapia
- Chemioterapia
- Immunologia
- Allergie
- Medicina cardiovascolare
- Medicina muscoscheletrica
- Ematologia
- Endocrinologia
- Diabete
- Gastroenterologia
- Epatologia
- Dermatologia
- Medicina dell'apparato respiratorio
- Reumatologia
- Neurologia e neurofisiologia clinica
- Otorinolaringoiatria
- Audiologia e otologia
- Oftalmologia
- Nefrologia
- Emodialisi
- Urologia e medicina urogenitale
- Ginecologia e ostetricia
- Medicina materno-fetale
- Pediatria
- Neonatologia
- Geriatria
- Terapia genica
- ALTRE BRANCHE DELLA MEDICINA
- Anestesiologia
- Dolore e terapia del dolore
- Medicina palliativa
- Odontoiatria
- Chirurgia orale e maxillofacciale
- Patologia
- Citopatologia
- Istopatologia
- Microbiologia e virologia medica
- Parassitologia medica
- Farmacologia
- Tossicologia
- Psicofarmacologia
- Psichiatria
- Psicologia clinica
- Psicoterapia
- Medicina d'urgenza e pronto soccorso
- Traumi e stati di shock
- Ustioni
- Terapia intensiva
- Medicina nucleare
- Diagnostica per immagini
- Ultrasuoni
- Risonanza magnetica nucleare (RMN/RMI)
- Radiologia
- Tomografia
- Medicina legale
- Medicina ambientale
- Medicina aeronautica e spaziale
- Medicina iperbarica e delle immersioni
- Medicina del lavoro
- Medicina tropicale
- Medicina sportiva e traumi sportivi
- Terapia e terapeutica
- Disordini alimentari e relativa terapia
- Obesità: trattamento e terapia
- Disordini della parola e del linguaggio e relativa terapia
- Dipendenze e relativa terapia
- Disordini del sonno e relativa terapia
- CHIRURGIA
- INFERMIERISTICA E SERVIZI AUSILIARI
- Infermieristica
- Fondamenti e competenze dell'infermieristica
- Ricerca e teoria dell'infermieristica
- Relazioni tra infermiere e paziente
- Specializzazioni infermieristiche
- Infermieristica d'urgenza e di pronto soccorso
- Infermieristica della terapia intensiva
- Infermieristica pediatrica
- Infermieristica geriatrica
- Infermieristica psichiatrica
- Infermieristica chirurgica
- Infermieristica delle cure terminali
- Infermieristica farmacologica
- Infermieristica sociale
- Infermieristica delle comunità
- Gestione e dirigenza infermieristica
- Ostetricia
- Metodi di parto
- Pronto soccorso e servizi paramedici
- Terapia della mano e del piede
- Farmacia e somministrazione dei farmaci
- Optometria, ottici
- Fisioterapia
- Terapia del lavoro
- Terapia creativa (es. arte, musica, recitazione)
- Consulenza medica
- Riabilitazione
- Riabilitazione: lesioni cerebrali e spinali
- Ingegneria biomedica
- Ortottica
- Protesica
- MEDICINA: GUIDE ALLO STUDIO E ALLA REVISIONE E OPERE DI CONSULTAZIONE
- MEDICINA COMPLEMENTARE
- MEDICINA VETERINARIA
- Medicina veterinaria: piccoli animali (animali domestici)
- Medicina veterinaria: grandi animali (animali domestici e di allevamento)
- Medicina veterinaria equina
- Medicina veterinaria: animali da laboratorio
- Medicina veterinaria: animali esotici e di zoo
- Medicina veterinaria: anatomia e fisiologia
- Medicina veterinaria: patologia e istologia
- Medicina veterinaria: nutrizione
- Medicina veterinaria: malattie infettive e relativa terapia
- Medicina veterinaria: batteriologia, virologia, parasitologia
- Medicina veterinaria: farmacologia
- Medicina veterinaria: radiologia
- Medicina veterinaria: chirurgia
- Medicina veterinaria: anestesiologia
- Medicina veterinaria: odontoiatria
- Medicina veterinaria: infermieristica
- Medicina veterinaria: medicina alternativa
- MEDICINA GENERALE
- DIRITTO
- GIURISPRUDENZA E ARGOMENTI D'INTERESSE GENERALE
- Giurisprudenza e filosofia del diritto
- Sistemi legislativi
- Common Law (Leggi e consuetudini non scritte)
- Diritto civile, diritto codificato
- Diritto romano
- Diritto islamico
- Diritto ecclesiastico (canonico)
- Diritto comparato
- Diritto e società
- Diritto e generi sessuali
- Criminologia: aspetti legali
- Competenze e pratica legale
- Avvocatura
- Professioni paralegali
- Professione legale: argomenti d'interesse generale
- Etica legale e condotta professionale
- Diritto applicato alle altre professioni
- Storia del diritto
- DIRITTO INTERNAZIONALE
- Diritto internazionale pubblico
- Trattati internazionali
- Diritto diplomatico
- Giurisdizione e immunità
- Diritto internazionale dei territori e degli stati
- Diritto del mare
- Diritto internazionale del commercio e dell'economia
- Dazi
- Investimenti internazionali e controversie correlate
- Diritto internazionale: ambiente
- Diritto internazionale: diritti umani
- Diritto internazionale umanitario
- Organizzazioni e istituzioni internazionali
- Diritto penale internazionale
- Diritto internazionale: trasporti, comunicazioni e commercio
- Diritto internazionale aeronautico e aerospaziale
- Diritto commerciale transnazionale
- Diritto internazionale marittimo
- Diritto internazionale: comunicazioni e telecomunicazioni
- Diritto privato internazionale e conflitti di legislazione
- Risoluzione delle controversie internazionali
- Tribunali e procedimenti internazionali
- Arbitrato internazionale
- Rapporti di diritto internazionale
- DIRITTO DI SPECIFICHE GIURISDIZIONI
- Sistema legale: argomenti d'interesse generale
- Tribunali e procedimenti
- Potere giudiziario
- Procedura civile, controversie legali e risoluzione dei contenziosi
- Risarcimenti civili
- Danni e compensazioni
- Ingiunzioni e altre prescrizioni
- Procedura civile: diritto probatorio
- Arbitrato, mediazione e risoluzione alternativa delle controversie
- Sistema legale: costi e finanziamenti
- Regolazione delle professioni legali
- Diritto privato, diritto civile: opere generali
- Diritto societario, commerciale e della competizione
- Diritto commerciale
- Diritto commerciale: franchising
- Diritto commerciale: commercio elettronico
- Diritto commerciale: vendita
- Diritto commerciale: esternalizzazione della mano d'opera, outsourcing
- Diritto commerciale: navigazione
- Diritto commerciale: aviazione
- Diritto societario
- Diritto societario: acquisizioni e fusioni
- Diritto delle associazioni di imprese
- Diritto della concorrenza, diritto antitrust
- Diritto dei contratti
- Diritto della rappresentanza commerciale
- Diritto degli approvvigionamenti e delle forniture di beni e servizi
- Diritto delle costruzioni e dell'ingegneria
- Diritto dell'energia e delle risorse naturali
- Diritto costituzionale e amministrativo
- Diritto: cittadinanza e nazionalità
- Diritto: immigrazione
- Diritto: asilo
- Costituzione
- Diritto: diritti umani e libertà civili
- Diritto: privacy
- Diritto: libertà di espressione
- Diritto: libertà di informazione
- Poteri del governo
- Diritto amministrativo
- Procedura e tribunali amministrativi
- Diritto militare e della difesa
- Revisione giudiziale
- Pratica parlamentare e legislativa
- Diritto elettorale
- Diritto degli enti locali
- Diritto e procedura penale
- Diritto giudiziario penale
- Reati conto lo stato
- Reati contro la persona
- Diritto sulle molestie sessuali
- Reati contro la proprietà
- Frodi
- Diritto penale minorile
- Reati contro la salute, la sicurezza e l'ordine pubblico
- Codice della strada, contravvenzioni al codice della strada
- Diritto sul terrorismo
- Procedura penale
- Sentenze e pene
- Procedura penale: diritto probatorio
- Procedure di polizia
- Diritto del lavoro
- Diritto del lavoro: discriminazioni
- Diritto sulla sicurezza e salute nel lavoro
- Diritto delle relazioni industriali e sindacali
- Contratti di lavoro
- Diritto dei mezzi di comunicazione di massa e dello spettacolo
- Diritto sulla diffamazione e la calunnia
- Diritto dello sport
- Diritto della pubblicità, del marketing e della sponsorizzazione
- Diritto dell'ambiente, dei trasporti e della pianificazione urbanistica
- Diritto dell'agricoltura
- Diritto sugli animali
- Diritto ambientale
- Legislazione sulla conservazione della natura
- Diritto dei trasporti
- Autostrade
- Diritto sulla pianificazione urbanistica
- Amministrazione fiduciaria
- Diritto di famiglia
- Diritto di famiglia: matrimonio e divorzio
- Diritto di famiglia: convivenza
- Diritto di famiglia: unioni di persone dello stesso sesso
- Diritto di famiglia: minori
- Diritto finanziario
- Diritto contabile
- Diritto bancario
- Bancarotta e insolvenza
- Diritto e regolazione del mercato dei capitali e dei titoli
- Diritto e regolazione dei servizi finanziari
- Diritto delle assicurazioni
- Diritto della previdenza
- Diritto dell'informatica e delle comunicazioni
- Diritto sulla protezione dei dati
- Diritto della proprietà intellettuale
- Diritto del copyright
- Diritto dei brevetti
- Diritto dei marchi di fabbrica
- Diritto sulle informazioni confidenziali
- Diritto della proprietà
- Diritto della proprietà immobiliare e terriero
- Diritto della proprietà e ipotecario
- Diritto delle locazioni
- Diritto delle cessioni
- Diritto delle stime e valutazioni
- Diritto sull'abitazione
- Diritto: proprietà personali
- Diritto sociale
- Diritto sulla beneficenza
- Diritto dell'educazione
- Diritto della sicurezza sociale e dell'assistenza sociale
- Diritto della previdenza sociale
- Diritto della salute e sicurezza pubblica
- Diritto medico e della sanità
- Diritto della salute mentale
- Controllo delle medicine e dei dispositivi sanitari
- Diritto sui disabili
- Diritto sugli anziani
- Diritto: tutela dei consumatori
- Diritto delle concessioni, del gioco d'azzardo e dei circoli
- Diritto fiscale e tributario
- Tassazione delle imprese
- Tassazione delle persone
- Imposte di vendita e doganali
- Tassazione di fondazioni e proprietà
- Illeciti, Reati
- Negligenza
- Molestie
- Lesioni personali
- Testamenti e successioni
- Fonti primarie del diritto
- Precedenti legali
- Legislazione
- DIRITTO: GUIDE ALLO STUDIO E ALLA PREPARAZIONE DEGLI ESAMI
- GIURISPRUDENZA E ARGOMENTI D'INTERESSE GENERALE
- ARTI
- Buoni Regalo
- Prodotti Enogastronomici
- Novità Narrativa
- Novità Saggistica
- Novità Ragazzi
- Promozioni
Elenco dei prodotti per marca Aracne
Mostrando 1567-1584 di 2342 element(s)